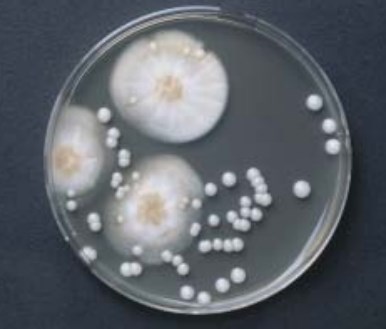

Description
Oxytetracyclin-Glucose-Yeast Extract (OGYE) Agar Base
Medium for the selective isolation and enumeration of yeasts and moulds in foods.
Oxytetracycline-Glucose-Yeast Extract Agar (OGYE Agar) is described by MOSSEL et al. (1962, 1970) used for the isolation and enumeration of yeasts and moulds in foods.
The medium complies with ISO 6611 and 13681.
Mode of action
The base medium allows good growth of yeasts and moulds.
Oxytetracycline inhibits the growth of bacteria.
Typical composition (g/litre)
Yeast Extract 5.0;
glucose (dextrose) 20.0;
Agar-Agar 12.0.
Preparation
Suspend 18.5 g in 500 ml of purified water. Heat to boiling to dissolve completely. Autoclave at 121°C for 15 minutes.
Cool the medium to 45-50°C and aseptically add the contents of 1 vial OGYE Selective Supplement. Mix well and pour into plates.
pH: 6.6 ±0.2 at 25°C
The prepared medium is clear and slight yellowish-brown in colour.
Experimental procedure and evaluation
The plates are inoculated using the pour-plate method or the surface spreading method.
Incubation: up to 5 days at 20-25°C
Count the number of colonies per plate. Calculate the dilution factor into the final count for the sample tested.

Reviews
There are no reviews yet.